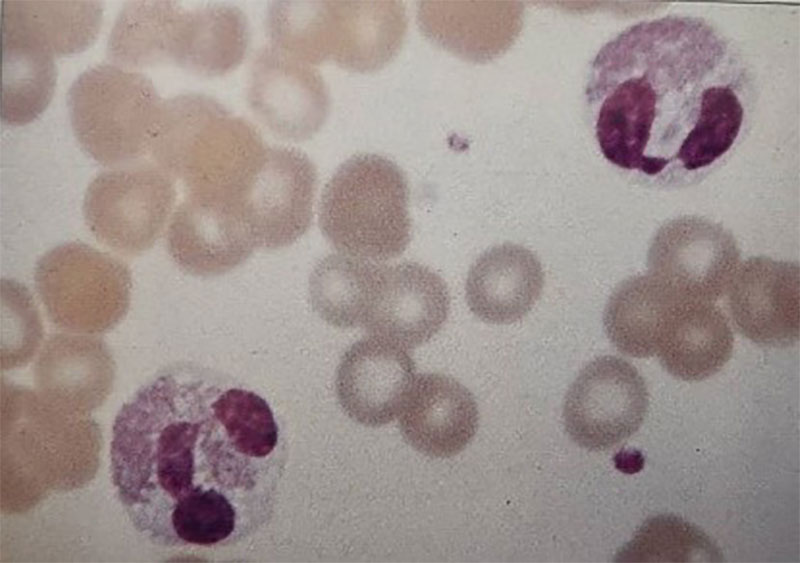

مطالعه موردی بیمار شماره 55 ، تشخیص شما چیست؟
شرح حال بیمار
یک بانوی ۳۵ ساله متوجه یک تورم بدون درد در سمت چپ گردن خود شده است که بیش از ۴ هفته وجود داشته و بهآرامی در حال بزرگ شدن است. به همین دلیل به یک مرکز درمانی مراجعه کرد.
او هیچ سابقهی بیماری خاصی ندارد و تب نیز نداشته است. در معاینهی فیزیکی، یک غدهی لنفاوی متحرک منفرد (به اندازهی 1 × 0.5 سانتیمتر) در مثلث قدامی سمت چپ گردن لمس میشود. غدههای لنفاوی دیگری لمس نمیشوند و کبد و طحال نیز قابل لمس نیستند.
نتایج آزمایشات او به شرح زیر است:
| هموگلوبین (Hb) | 11.9 g/dl |
| WBC | 8.6 × 10⁹ /L |
| نوتروفیلها | 5.3 × 10⁹ /L |
| ائوزینوفیلها | 1.1 × 10⁹ /L |
| لنفوسیتها | 2.1 × 10⁹ /L |
| پلاکتها | 165 × 10⁹ /L |

سوالات و پاسخها
1. تفسیر شما از گسترش خون محیطی بیمار ( شکل 55a) چیست؟ علت این موارد کدام است؟
در گسترش خون محیطی بیمار، افزایش تعداد ائوزینوفیلها دیده میشود. مقدار طبیعی کمتر از 109×0.4 بر لیتر است.
علل مهم ائوزینوفیلی عبارتند از:
- واکنشهای آلرژیک (حساسیت دارویی، آسم، اگزما)
- عفونتهای انگلی (Parasitic infections)
- بیماریهای بافت همبند و عروقی (Collagen vascular diseases) مانند پلیآرتریت ندوزا
- بیماریهای گرانولوماتوز (Granulomatous conditions) مانند سارکوئیدوز
- نئوپلاسمها (Neoplasms)
- نئوپلاسمهای خونی مانند لنفوم یا لوسمی لنفوبلاستیک حاد (ALL)
- نئوپلاسمهای غیرخونی مانند سرطان پستان، نایژه (Bronchus)
- سندرم ائوزینوفیلی اولیه یا ایدیوپاتیک
2. نظر شما دربارهی بیوپسی غده لنفاوی (شکل 55c,55b) چیست؟
نمونهبرداری از غده لنفاوی (بیوپسی) نشاندهندهی ارتشاح سلولی مختلط (mixed cellular infiltrate) همراه با حضور سلولهای بزرگ و شاخص Reed–Sternberg است.
3. تشخیص چیست؟
بیمار احتمالا به بیماری هوچکین (Hodgkin’s disease) مبتلا است.
4. چه بررسیهای بیشتری لازم است؟
تعیین مرحلهی بیماری (Staging) باید شامل موارد زیر باشد:
- شرح حال کامل از جمله علائم سیستمیک موسوم به علائم B (خارش، کاهش وزن، تب)
- معاینهی فیزیکی و سایر بررسیها
بررسیهای آزمایشگاهی و تصویربرداری شامل
- عکس قفسه سینه (Chest X-ray) (شکل 55d)
- سیتیاسکن قفسه سینه و شکم
- آسپیراسیون و بیوپسی مغز استخوان
- آزمایش کامل خون و غربالگری بیوشیمیایی شامل:
- ESR
- کلسیم
- ایمونوگلوبولینها
- تستهای عملکرد کبد
- LDH
گاهی در موارد خاص و انتخاب شده، لاپاراتومی جهت مرحلهبندی انجام میشود (هرچند امروزه نادر است).
توضیحات تکمیلی
این فرد بیماری مدیاستینال داشت (تصویر55d) و با چهار دوره شیمی درمانی و بدنبال آن پرتودرمانی تحت درمان قرار گرفت. اگرچه در رادیوگرافی که 2سال بعد تهیه شد (تصویر55e) علایم بهبودی از بیماری هودجکین نشان داده شد اما شواهدی از افزایش سایه های دوطرفه در نواحی تحتانی دیده می شود و در بیمار پنمونیت ناشی از پرتودرمانی ایجاد شد که به درمان با استروئید پاسخ داد.




